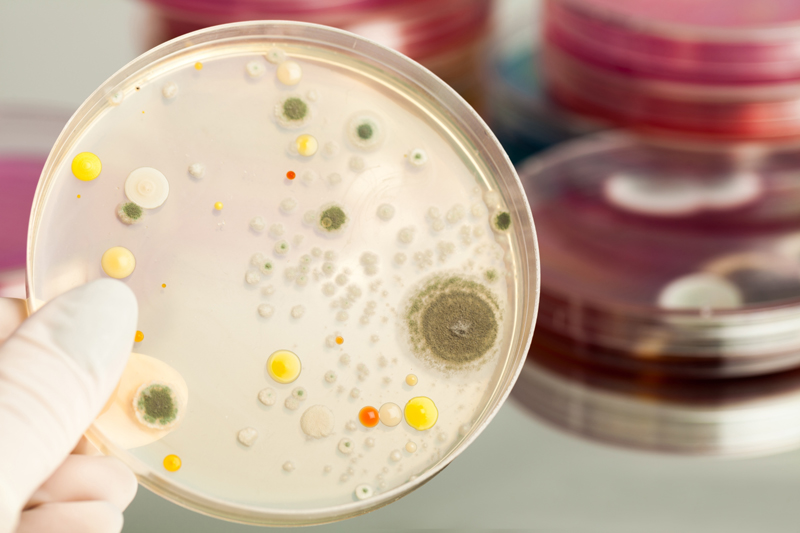
service details image

Molecular Biology & Genetic Engineering Training
Molecular Biology and Recombinant DNA or Genetic Engineering is widely used in biotechnology, medicine and research. Recombinant DNA is used to identify, map and sequence genes, and to determine their function. rDNA probes are employed in analyzing gene expression within individual cells, and throughout the tissues of whole organisms. Recombinant proteins are widely used as reagents in laboratory experiments and to generate antibody probes for examining protein synthesis within cells and organisms.
rDNA technologies will play a key role in preventing genetic diseases, producing targeted medicines and providing patients with less toxic pharmaceuticals. It will also impact agriculture and livestock as researchers find ways to optimise the genetic codes of plants and animals to resist diseases.
Course Goal
An aspirant would be able to have a comprehensive concepts on:
- Detailed Analysis of the biochemical mechanisms that control the maintenance
- Expression and evolution of prokaryotic and eukaryotic genomes.
- Gene Regulation
- DNA Replication
- Genetic Recombination
- mRNA translation
Course Curriculum
- Isolation of genomic DNA from plant/animal/bacteria/fungi cells
- Isolation of total RNA from plant/animal/bacteria/fungi cells
- Isolation of plasmid DNA from bacterial cells.
- Quantitative and qualitative analysis of nucleic acids from plants/animals/bacteria/fungi cells
- Molecular weight analysis of nucleic acids with agarose gel electrophoresis
- Isolation of mRNA and cDNA preparation
- Competent cell preparation
- Cloning and expression of genes in bacterial cells
- Screening and selection of bacterial cells for cloned cells
- Restriction and digestion of cloned gene
- Competent cell preparation
- Cloning and expression of genes in bacterial cells
- Screening and selection of bacterial cells for cloned cells
- Restriction and digestion of cloned gene
- Elusion of the gene from gel
- Transformation of gene to the nitrocellulose membrane
- Real PCR analysis
Need Help?
-
Windsor Plaza, Vegitable Market Road, New Nallakunta Center,Hyderabad.
